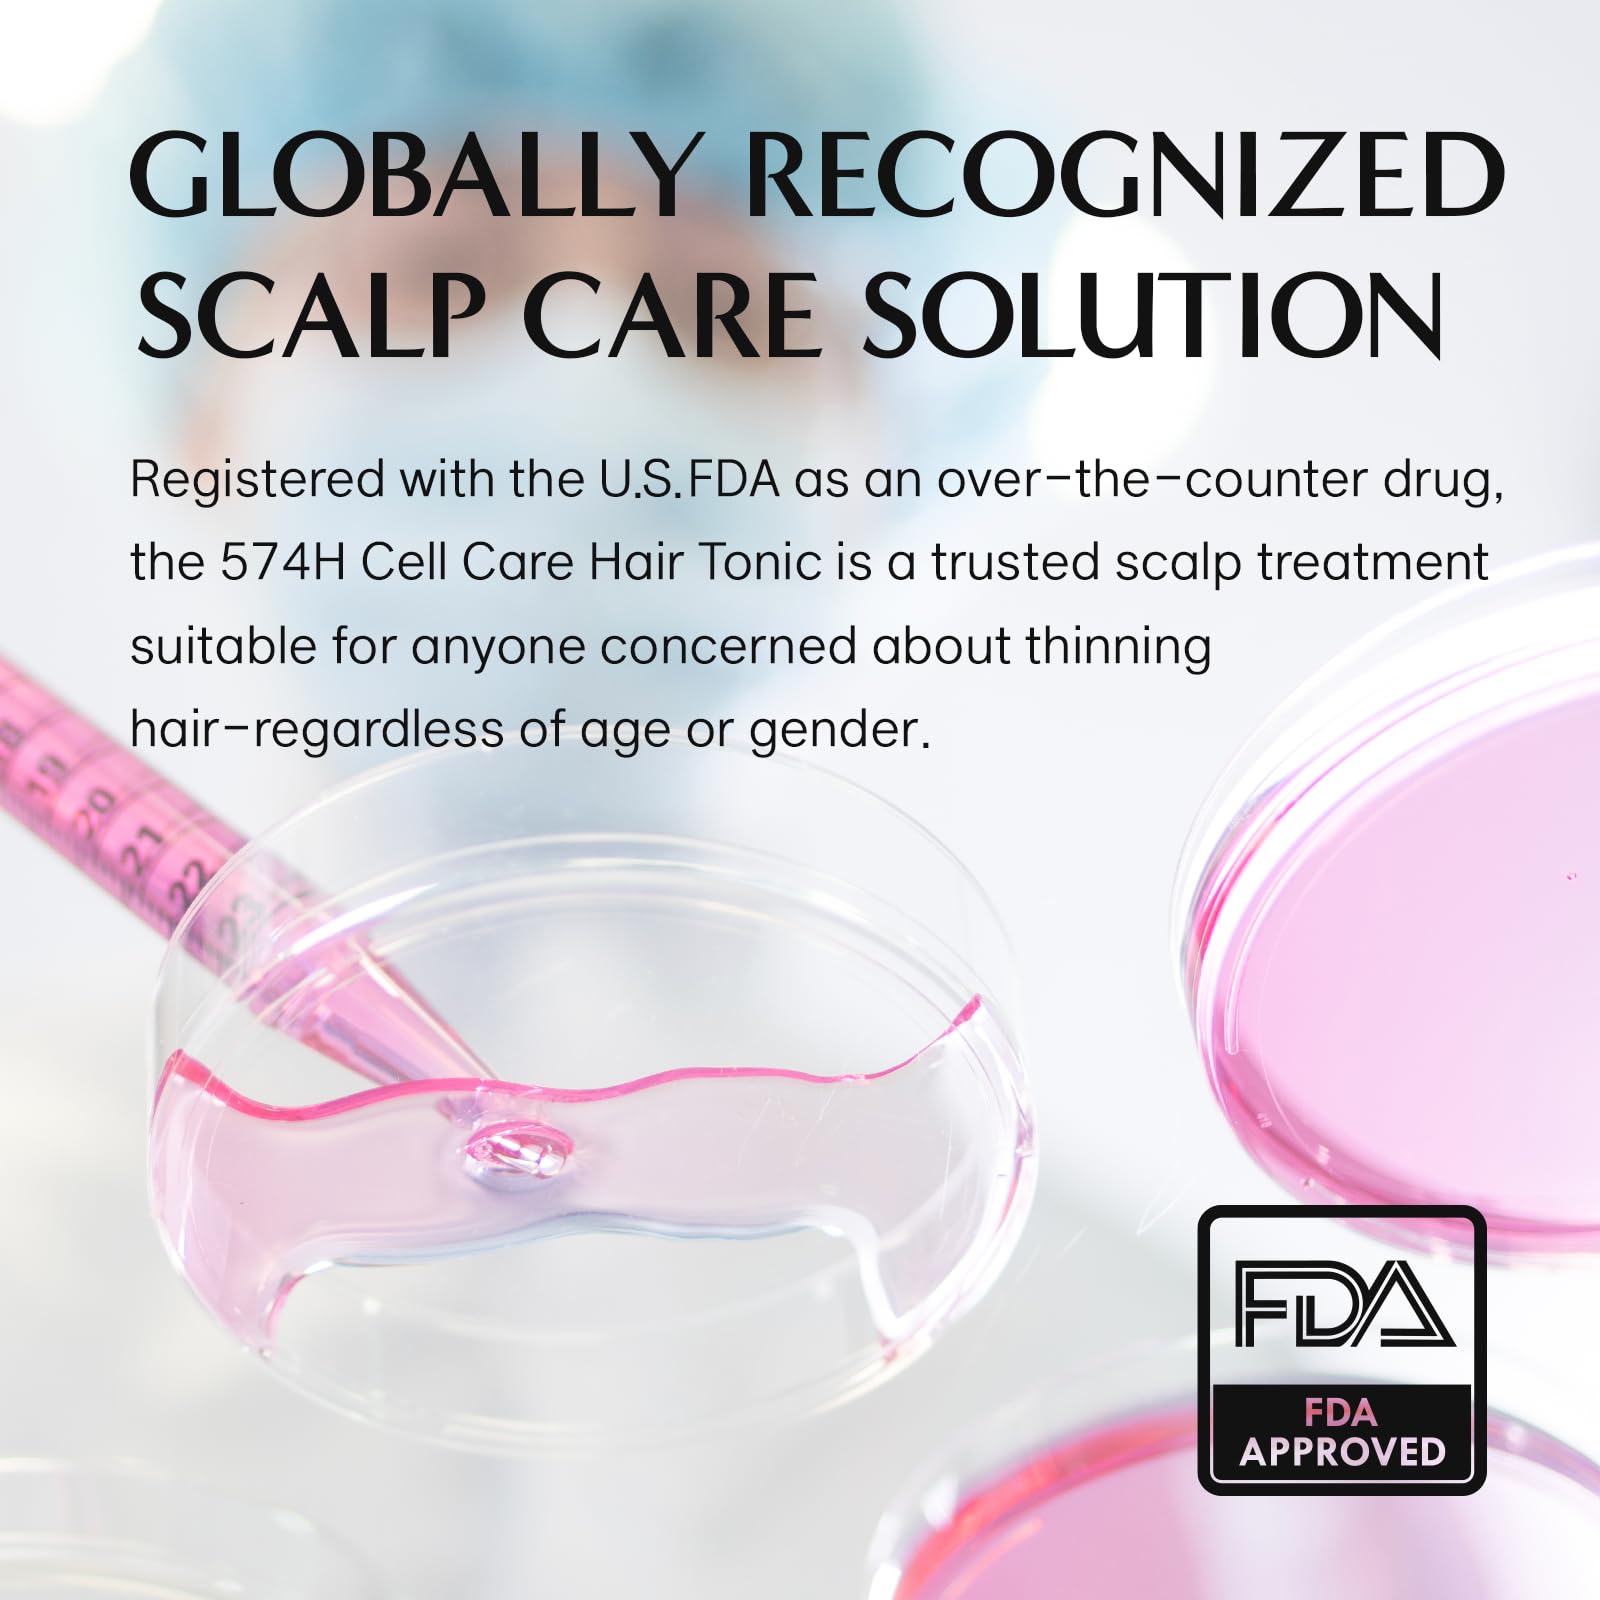

CELINO
CELONIA NGF 574H Hair Tonic, Korean Primed Bio Stem Cell Hair And Scalp Treatment Serum For Hair Growth And healthy Scalp, Non Greasy Non Oily, Anti Hair Loss, Reduce Flaky Itch And Dry Scalp 50ml
CELONIA NGF 574H Hair Tonic, Korean Primed Bio Stem Cell Hair And Scalp Treatment Serum For Hair Growth And healthy Scalp, Non Greasy Non Oily, Anti Hair Loss, Reduce Flaky Itch And Dry Scalp 50ml
Regular price
$135.00 CAD
Regular price
Sale price
$135.00 CAD
Unit price
per
Couldn't load pickup availability
Brand: CELINO
Color: Clear
Features:
- Powered by 574H Stem Cell Innovation, Formulated with hair-optimized bio cell conditioned media, developed through 574 experimental conditions for targeted performance.
- Strengthens Roots & Revitalizes Scalp, Enriched with patented active ingredients to support scalp health, improve hair vitality, and reduce visible signs of thinning.
- Fast-Absorbing, Lightweight Formula, Designed for daily use, this non-greasy tonic absorbs quickly, delivering nutrients deep into the scalp without buildup.
- Supports Regrowth & Hair Loss Symptom Relief, Helps promote new hair growth while alleviating symptoms of hair thinning—ideal for both men and women.
- Safe for Sensitive Scalps, Clinically tested and free from harsh ingredients. Gentle yet effective care for fragile, irritated, or sensitive scalp conditions.
EAN: 8809661471516
Package Dimensions: 4.7 x 1.7 x 1.5 inches
Materials
Materials
Shipping & Returns
Shipping & Returns
Dimensions
Dimensions
Care Instructions
Care Instructions








Image with text
Pair text with an image to focus on your chosen product, collection, or blog post. Add details on availability, style, or even provide a review.
-
Free Shipping
Pair text with an image to focus on your chosen product, collection, or blog post. Add details on availability, style, or even provide a review.
-
Hassle-Free Exchanges
Pair text with an image to focus on your chosen product, collection, or blog post. Add details on availability, style, or even provide a review.